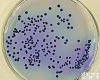
<em>乙酰胺</em><em>肉汤</em> GB 250g/瓶

乙酰胺肉汤,乙酰胺肉汤,乙酰胺肉汤
- 产地:进口,国产,厂家
- 供应商:青岛日水生物技术有限公司
- 供应商报价:180
- 标签:乙酰胺肉汤,乙酰胺肉汤,乙酰胺肉汤,180,青岛日水生物技术有限公司
乙酰胺肉汤
产品编号:11703
GB/T8538—2008饮用天然矿泉水检验方法,铜绿假单胞菌的产氨试验
乙酰胺肉汤价格厂家供货,价格Z低,马上我们:4006177016,或或咨询客服,工作人员随时为您服务
所属种类:GB/T8538—2008饮用天然矿泉水检验方法
包装规格:250g/瓶,也可以根据您的要求定做
存条件及要求:常温/低温,避光我们是乙酰胺肉汤厂家优质供应商,专业为生物研究、医药、食品厂、化妆品厂和质量检验等行业提供微生物干粉培养基、显色培养基、即用型培养基,一次性平板,表面接触碟和各种配套试剂的厂家,有关乙酰胺肉汤配方,微生物培养基,食品药品质量检验检测方法方面的问题,均可以咨询我们,期待着您的来电,详情请登录http://www.qdnissui.net查看
我们还提供其他产品:11702,金氏B培养基,250g/瓶,绿脓杆菌产荧光特性鉴定
21702,甘油,1ml×10支/盒,每支用于100ml11701或11702中
21701,萘啶酮酸,1.5mg×10支/盒,每支用于100ml11701中
11701,假单胞菌琼脂基础培养基/CN琼脂,250g/瓶,用于绿脓杆菌菌滤膜法测定
10906,胆汁液态培养基,250g/瓶,用于粪链球菌验证
10905,脑-心浸萃琼脂培养基,250g/瓶,用于粪链球菌验证
厂家现货提供乙酰胺肉汤货源,质量好,价格低,请我们,赶快订购吧!